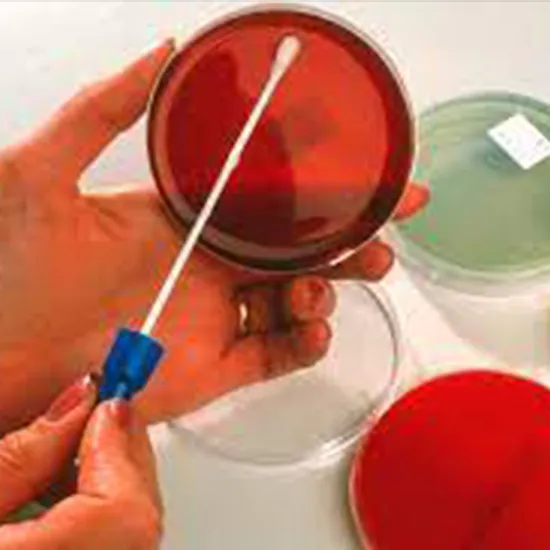
Culture & Sensitivity - Wound Swab

تفاصيل التحليل
مسحة ومزرعة وحساسية الجروح
تحديد دقيق لنوع البكتيريا المسببة لالتهاب الجروح وتأخر التئامها، مما يضمن اختيار المضاد الحيوي المناسب لتسريع عملية الشفاء وتجنب العدوى.
الصورة التوضيحية المرتبطة بهذا التحليل